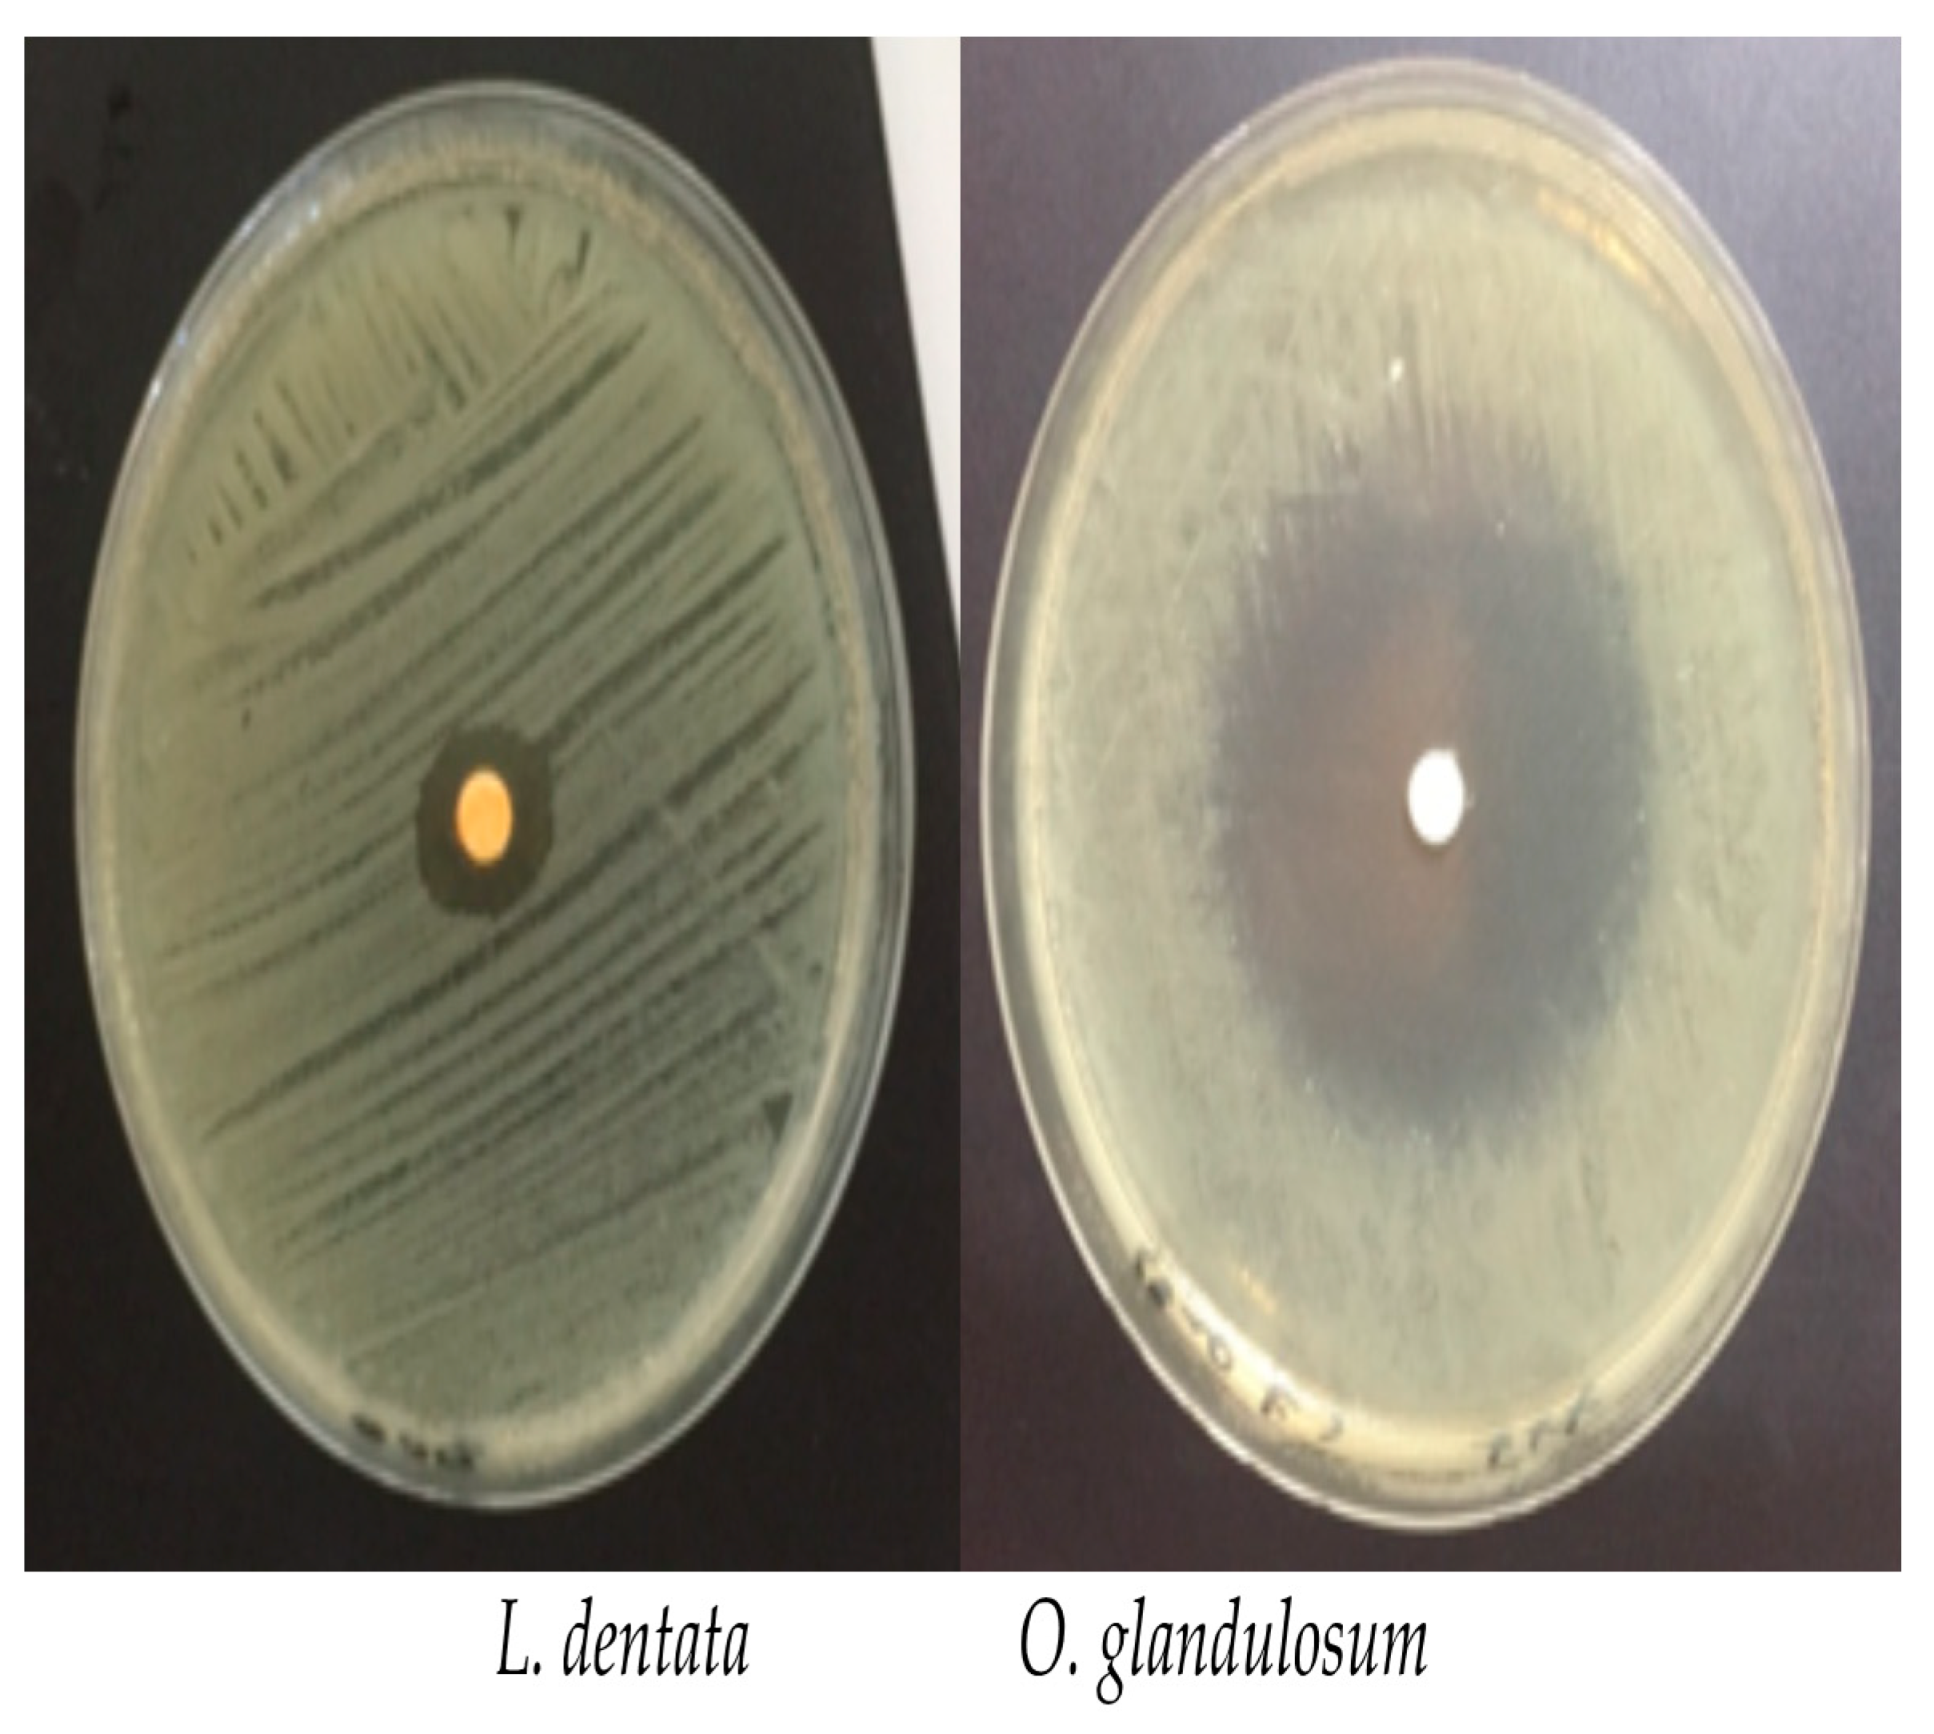
Applsci 11 05688 g001 Applsci 11 05688 g001

Chemical Composition and Biological Activities of Oregano and Lavender Essential Oils
Abstract
1. Introduction
2. Materials and Methods
2.1. Plant Material and Essential Oils Extraction
2.2. Bacterial Strains
2.3. Antibacterial Activity Test
2.3.1. Disc Diffusion Assay
2.3.2. Determination of MIC and MBC
2.4. Gas Chromatography/Mass Spectrometry (GC/MS) Analysis
2.5. Measurement of Release of 260-nm Absorbing Cellular Materials
2.6. Transmission Electron Microscopy TEM
2.7. Blood Collection and Polymorphonuclear Leukocytes (PMN) Isolation
2.8. Cell Viability Test
2.9. Reactive Oxygen Species ROS Generation
2.10. Statistical Analysis
3. Results
3.1. Essential Oils Extraction
3.2. Gas Chromatography/Mass Spectrometry (GC/MS) Analysis
3.3. Antibacterial Activity
3.4. Measurement of Release of 260 nm Absorbing Cellular Materials
3.5. TEM (Transmission Electron Microscopy) Observation
3.6. Cell Viability Test
3.7. Reactive Oxygen Species (ROS) Generation
4. Discussion
Author Contributions
Funding
Institutional Review Board Statement
Informed Consent Statement
Acknowledgments
Conflicts of Interest
References
- Bertella, A.; Benlahcen, K.; Abouamama, S.; Pinto, D.C.; Maamar, K.; Kihal, M.; Silva, A.M.S. Artemisia herba-alba Asso. essential oil antibacterial activity and acute toxicity. Ind. Crop. Prod. 2018, 116, 137–143. [Google Scholar] [CrossRef]
- Nabti, L.Z.; Sahli, F.; Laouar, H.; Olowo-Okere, A.; Wandjou, J.G.N.; Maggi, F. Chemical Composition and Antibacterial Activity of Essential Oils from the Algerian Endemic Origanum glandulosum Desf. against Multidrug-Resistant Uropathogenic E. coli Isolates. Antibiotics 2020, 9, 29. [Google Scholar] [CrossRef] [PubMed]
- Khalifa, A.B.H.; Khedher, M. Epidémiologie des souches de Klebsiella spp. uropathogènes productrices de β-lactamases à spectre élargi dans un hôpital universitaire Tunisien, 2009. Pathol. Biol. 2012, 60, e1–e5. [Google Scholar] [CrossRef] [PubMed]
- Wyres, K.L.; Holt, K.E. Klebsiella pneumoniae Population Genomics and Antimicrobial-Resistant Clones. Trends Microbiol. 2016, 24, 944–956. [Google Scholar] [CrossRef] [PubMed]
- Markovska, R.; Stoeva, T.; Boyanova, L.; Stankova, P.; Pencheva, D.; Keuleyan, E.; Murjeva, M.; Sredkova, M.; Ivanova, D.; Lazarova, G.; et al. Dissemination of successful international clone ST15 and clonal complex 17 among Bulgarian CTX-M-15 producing K. pneumoniae isolates. Diagn. Microbiol. Infect. Dis. 2017, 89, 310–313. [Google Scholar] [CrossRef]
- Panda, P.; Jhon, N.; Sao, S.; Information, P.E.K.F.C. Antibiogram, ESBL production and carbapenemase detection of Klebsiella spp. in hospital-acquired infection. Apollo Med. 2016, 13, 156–162. [Google Scholar] [CrossRef]
- Akturk, H.; Sutcu, M.; Somer, A.; Aydın, D.; Cihan, R.; Ozdemir, A.; Coban, A.; Ince, Z.; Citak, A.; Salman, N. Carbapenem-resistant Klebsiella pneumoniae colonization in pediatric and neonatal intensive care units: Risk factors for progression to infection. Braz. J. Infect. Dis. 2016, 20, 134–140. [Google Scholar] [CrossRef]
- Cescutti, P.; De Benedetto, G.; Rizzo, R. Structural determination of the polysaccharide isolated from biofilms produced by a clinical strain of Klebsiella pneumoniae. Carbohydr. Res. 2016, 430, 29–35. [Google Scholar] [CrossRef]
- Delatour, C.; Chalvon, N.; Prieur, N.; Mateu, P. A history of community-acquired hypervirulent Klebsiella pneumoniae severe sepsis. Anaesth. Crit. Care Pain Med. 2018, 37, 273–275. [Google Scholar] [CrossRef]
- Hauser, N.; Tanner, E.; Keuroghlian, M.; Koduri, L. A case of Klebsiella oxytoca endocarditis in an intravenous drug user. IDCases 2017, 9, 77–78. [Google Scholar] [CrossRef]
- Huang, Y.-T.; Jiang, J.-Y.; Hsu, M.-S.; Hsu, H.-S.; Liao, C.-H.; Hsueh, P.-R. The prevalence of rectal carriage of Klebsiella pneumoniae amongst diabetic patients and their clinical relevance in Taiwan: A five-year prospective study. J. Microbiol. Immunol. Infect. 2018, 51, 510–518. [Google Scholar] [CrossRef]
- Khodadadian, R.; Rahdar, H.A.; Javadi, A.; Safari, M.; Khorshidi, A. Detection of VIM-1 and IMP-1 genes in Klebsiella pneumoniae and relationship with biofilm formation. Microb. Pathog. 2018, 115, 25–30. [Google Scholar] [CrossRef] [PubMed]
- Boniface, Y.; Jean-Pierre, N.; Philippe, S.; Félicien, A.; Dominique, S. Etude chimique et activités antimicrobiennes d’extraits volatils des feuilles et fruits de Xylopia aethiopica (DUNAL) A. Richard contre les pathogènes des denrées alimentaires. J. Soc. Ouest-Afr. Chim. 2010, 29, 19–27. [Google Scholar]
- Kacaniova, M.; Vukovič, N.; Hleba, L.; Bobková, A.; Pavelková, A.; Rovná, K.; Arpasova, H. Antimicrobial and Antiradicals Activity of Origanum vulgare L. and Thymus Vulgaris Essential Oils. J. Microbiol. Biotechnol. Food Sci. 2012, 2, 263–271. [Google Scholar]
- Faleiro, L.; Miguel, G.; Guerrero, C.; Brito, J. Antimicrobial activity of essential oils of Rosmarinus officinalis L., Thymus mastichina (L) L. ssp Mastichina and Thymus albicans Hofmanns & Link. Acta Hortic. 1999, 45–48. [Google Scholar] [CrossRef]
- Alitonou, G.; Avlessi, F.; Sohounhloue, D.; Agnaniet, H.; Bessiere, J.-M.; Menut, C. Investigations on the essential oil of Cymbopogon giganteus from Benin for its potential use as an anti-inflammatory agent. Int. J. Aromather. 2006, 16, 37–41. [Google Scholar] [CrossRef]
- De Oliveira, J.R.; De Castro, V.C.; Vilela, P.D.G.F.; Camargo, S.E.A.; Carvalho, C.A.T.; Jorge, A.O.C.; De Oliveira, L.D. Cytotoxicity of Brazilian plant extracts against oral microorganisms of interest to dentistry. BMC Complement. Altern. Med. 2013, 13, 208. [Google Scholar] [CrossRef]
- Rebey, I.B.; Bourgou, S.; Tounsi, M.S.; Fauconnier, M.L.; Ksouri, R. Phytochemical composition and antioxidant activity of Lavandula dentate extracts. J. New Sci. 2017, 39, 2096–2105. [Google Scholar]
- Naghibi, F.; Mosadegh, M.; Mohammadi, M.S.; Ghorbani, A.B. Labiatae Family in Folk Medicine in Iran: From Ethnobotany to Pharmacology. Iran. J. Pharm. Res. 2005, 4, 63–79. [Google Scholar]
- Ali, H.; Al-Khalifa, A.R.; Aouf, A.; Boukhebti, H.; Farouk, A. Effect of nanoencapsulation on volatile constituents, and antioxidant and anticancer activities of Algerian Origanum glandulosum Desf. essential oil. Sci. Rep. 2020, 10, 1–9. [Google Scholar] [CrossRef]
- Bendahou, M.; Muselli, A.; Grignon-Dubois, M.; Benyoucef, M.; Desjobert, J.-M.; Bernardini, A.-F.; Costa, J. Antimicrobial activity and chemical composition of Origanum glandulosum Desf. essential oil and extract obtained by microwave extraction: Comparison with hydrodistillation. Food Chem. 2008, 106, 132–139. [Google Scholar] [CrossRef]
- Bekhechi, C.; Atik-Bekkara, F.; Abdelouahid, D.E. Composition et activité antibactérienne des huiles essentielles d’Origanum glandulosum d’Algérie. Phytothérapie 2008, 6, 153–159. [Google Scholar] [CrossRef]
- Belhattab, R.; Larous, L.; Figueiredo, A.C.; Santos, P.A.G.; Pedro, L.G. Origanum glandulosum Desf. grown wild in Algeria: Essential oil composition and glycosidic bound volatiles. Flavour Fragr. J. 2004, 20, 209–212. [Google Scholar] [CrossRef]
- Mechergui, K.; Jaouadi, W.; Coelho, J.A.; Serra, M.C.; Khouja, M.L. Biological activities and oil properties of Origanum glandulosum Desf: A review. Phytothérapie 2015, 14, 102–108. [Google Scholar] [CrossRef]
- Harfi, B.; Benahmed, A.; Karkour, L. Characterization of Origanum glandulosum Desf. Essential Oils Collected from Different Culture Conditions Towards Standardized ex situ Production. J. Essent. Oil Bear. Plants 2019, 22, 838–850. [Google Scholar] [CrossRef]
- Algieri, F.; Rodriguez-Nogales, A.; Vezza, T.; Garrido-Mesa, J.; Mesa, N.G.; Utrilla, M.P.; González-Tejero, M.R.; Casares-Porcel, M.; Mesa, J.M.; Contreras, M.D.M.; et al. Anti-inflammatory activity of hydroalcoholic extracts of Lavandula dentata L. and Lavandula stoechas L. J. Ethnopharmacol. 2016, 190, 142–158. [Google Scholar] [CrossRef]
- Bachiri, L.; Bammou, M.; Echchegadda, G.; Ibijbijen, J.; El Rhaffari, L.; Haloui, Z.; Nassiri, L. Composition Chimique et Activité Antimicrobienne des Huiles Essentielles de Deux Espèces de Lavande: Lavandula Dentata spp. Dentata et Lavandula Peduncultata spp. Pedunculata. Eur. Sci. J. ESJ 2017, 13, 293. [Google Scholar] [CrossRef]
- Bachiri, L.; Echchegadda, G.; Ibijbijen, J.; Nassiri, L. Etude Phytochimique et Activité Antibactérienne de Deux Espèces de Lavande Autochtones Au Maroc: «Lavandula stoechas L. et Lavandula dentata L.». Eur. Sci. J. ESJ 2016, 12. [Google Scholar] [CrossRef]
- Clevenger, J.F. Apparatus for the Determination of Volatile Oil. J. Am. Pharm. Assoc. 1928, 17, 345–349. [Google Scholar] [CrossRef]
- Cheurfa, M.; Allem, R.; Sebaihia, M.; Belhireche, S. Effet de l’huile essentielle de Thymus vulgaris sur les bactéries pathogènes responsables de gastroentérites. Phytothérapie 2013, 11, 154–160. [Google Scholar] [CrossRef]
- Bauer, A.W.; Kirby, W.M.; Sherris, J.C.; Turck, M. Antibiotic susceptibility testing by a standardized single disk method. Am. J. Clin. Pathol. 1966, 45, 493–496. [Google Scholar] [CrossRef]
- Khadir, A.; Bendahou, M.; Benbelaid, F.; Abdoune, M.A.; Abdelouahid, D.E. Pouvoir antimicrobien de Thymus lanceolatus Desf., récolté en Algérie. Phytothérapie 2013, 11, 353–358. [Google Scholar] [CrossRef]
- Bazargani, M.M.; Rohloff, J. Antibiofilm activity of essential oils and plant extracts against Staphylococcus aureus and Escherichia coli biofilms. Food Control 2016, 61, 156–164. [Google Scholar] [CrossRef]
- Flamini, G.; Pistelli, L.; Nardoni, S.; Ebani, V.V.; Zinnai, A.; Mancianti, F.; Ascrizzi, R.; Pistelli, L. Essential Oil Composition and Biological Activity of “Pompia”, a Sardinian Citrus Ecotype. Molecules 2019, 24, 908. [Google Scholar] [CrossRef] [PubMed]
- Bajpai, V.K.; Sharma, A.; Baek, K.-H. Antibacterial mode of action of Cudrania tricuspidata fruit essential oil, affecting membrane permeability and surface characteristics of food-borne pathogens. Food Control 2013, 32, 582–590. [Google Scholar] [CrossRef]
- Russi, S.; Maresca, V.; Zoppoli, P.; Aieta, M.; Marino, G.; Sgambato, A.; Ignomirelli, O.; Ciuffi, M.; Notarangelo, T.; Basile, A.; et al. Effect of Feijoa Sellowiana Acetonic Extract on Proliferation Inhibition and Apoptosis Induction in Human Gastric Cancer Cells. Appl. Sci. 2020, 10, 7756. [Google Scholar] [CrossRef]
- Di Napoli, M.; Maresca, V.; Varcamonti, M.; Bruno, M.; Badalamenti, N.; Basile, A.; Zanfardino, A. (+)-(E)-Chrysanthenyl Acetate: A Molecule with Interesting Biological Properties Contained in the Anthemis secundiramea (Asteraceae) Flowers. Appl. Sci. 2020, 10, 6808. [Google Scholar] [CrossRef]
- Boyle, W.; Chow, A. Isolation of Human Lymphocytes by a Ficoll Barrier Method. Transfusion 1969, 9, 151–155. [Google Scholar] [CrossRef]
- Kol, R.; Friedlander, M.; Riklis, E.; Raveh, D. Separation of Human Lymphocytes on Ficoll-Paque Gradients: Stimulation of Cells and Depletion of a Concanavalin-A Responsive Radioresistant Subpopulation. Radiat. Res. 1983, 95, 108. [Google Scholar] [CrossRef]
- Liu, Y.; Schubert, D. Cytotoxic Amyloid Peptides Inhibit Cellular 3-(4,5-Dimethylthiazol-2-yl)-2,5-Diphenyltetrazolium Bromide (MTT) Reduction by Enhancing MTT Formazan Exocytosis. J. Neurochem. 2002, 69, 2285–2293. [Google Scholar] [CrossRef]
- Notariale, R.; Basile, A.; Montana, E.; Romano, N.C.; Cacciapuoti, M.G.; Aliberti, F.; Gesuele, R.; De Ruberto, F.; Sorbo, S.; Tenore, G.C.; et al. Protamine-like proteins have bactericidal activity. The first evidence in Mytilus galloprovincialis. Acta Biochim. Pol. 2018, 65, 585–594. [Google Scholar] [CrossRef] [PubMed]
- Manna, A.; Saha, P.; Sarkar, A.; Mukhopadhyay, D.; Bauri, A.K.; Kumar, D.; Das, P.; Chattopadhyay, S.; Chatterjee, M. Malabaricone-A Induces A Redox Imbalance That Mediates Apoptosis in U937 Cell Line. PLoS ONE 2012, 7, e36938. [Google Scholar] [CrossRef] [PubMed]
- Mohamed, S.B.; Eddine, A.D. Antibacterial Activity of Essential Oils of Some Algerian Aromatic Plants Against Multidrug Resistant Bacteria. J. Essent. Oil Bear. Plants 2010, 13, 362–370. [Google Scholar] [CrossRef]
- Ouedrhiri, W.; Mounyr, B.; Harki, E.H.; Moja, S.; Greche, H. Synergistic antimicrobial activity of two binary combinations of marjoram, lavender, and wild thyme essential oils. Int. J. Food Prop. 2017, 20, 3149–3158. [Google Scholar] [CrossRef]
- Dammak, I.; Hamdi, Z.; El Euch, S.K.; Zemni, H.; Mliki, A.; Hassouna, M.; Lasram, S. Evaluation of antifungal and anti-ochratoxigenic activities of Salvia officinalis, Lavandula dentata and Laurus nobilis essential oils and a major monoterpene constituent 1,8-cineole against Aspergillus carbonarius. Ind. Crop. Prod. 2019, 128, 85–93. [Google Scholar] [CrossRef]
- Dob, T.; Dahmane, D.; Tayeb, B.; Chelghoum, C. Chemical composition of the essential oil of Lavandula dentata L. from Algeria. Int. J. Aromather. 2005, 15, 110–114. [Google Scholar] [CrossRef]
- Silva-Flores, P.G.; Pérez-López, L.A.; Rivas-Galindo, V.M.; Paniagua-Vega, D.; Galindo-Rodríguez, S.A.; Álvarez-Román, R. Simultaneous GC-FID Quantification of Main Components of Rosmarinus officinalis L. and Lavandula dentata Essential Oils in Polymeric Nanocapsules for Antioxidant Application. J. Anal. Methods Chem. 2019, 2019, 1–9. [Google Scholar] [CrossRef] [PubMed]
- Nabet, N.; Boudries, H.; Chougui, N.; Loupassaki, S.; Souagui, S.; Burló, F.; Hernández, F.; Carbonell-Barrachina, Á.A.; Madani, K.; Larbat, R. Biological activities and secondary compound composition from Crithmum maritimum aerial parts. Int. J. Food Prop. 2016, 20, 1843–1855. [Google Scholar] [CrossRef]
- Gonçalves, M.; Cruz, M.; Cavaleiro, C.; Lopes, M.; Salgueiro, L. Chemical, antifungal and cytotoxic evaluation of the essential oil of Thymus zygis subsp. sylvestris. Ind. Crop. Prod. 2010, 32, 70–75. [Google Scholar] [CrossRef]
- Nikolic, M.; Jovanović, K.K.; Marković, T.; Marković, D.; Gligorijević, N.; Radulović, S.; Soković, M. Chemical composition, antimicrobial, and cytotoxic properties of five Lamiaceae essential oils. Ind. Crop. Prod. 2014, 61, 225–232. [Google Scholar] [CrossRef]
- Dutra, T.V.; Castro, J.C.; de Menezes, J.L.; Ramos, T.R.; Prado, I.N.D.; Machinski, M.; Mikcha, J.M.G.; Filho, B.A.D.A. Bioactivity of oregano (Origanum vulgare) essential oil against Alicyclobacillus spp. Ind. Crop. Prod. 2019, 129, 345–349. [Google Scholar] [CrossRef]
- Hernández-González, M.; Berumen, C.P.; Ruíz, H.S.; Salazar, C.R.; Paz, J.H.; Olivas-Armendáriz, I.; Martel-Estrada, S.; González, C.R. Polysuccinimide functionalized with oregano’s essential oil extracts, an antimicrobial extended release bio-material. Mater. Lett. 2017, 191, 73–76. [Google Scholar] [CrossRef]
- Btissam, R.; Fatima, E.M.; Kamal, E.; Hassane, G.; Mohamed, N. Composition and Antibacterial Activity of Hydro-Alcohol and Aqueous Extracts Obtained from the Lamiaceae Family. Pharmacogn. J. 2017, 10, 81–91. [Google Scholar] [CrossRef]
- Yang, S.-K.; Yusoff, K.; Thomas, W.; Akseer, R.; Alhosani, M.S.; Abushelaibi, A.; Lim, E.; Lai, K.-S. Lavender essential oil induces oxidative stress which modifies the bacterial membrane permeability of carbapenemase producing Klebsiella pneumoniae. Sci. Rep. 2020, 10, 819. [Google Scholar] [CrossRef] [PubMed]
- Heydari, M.; Zanfardino, A.; Taleei, A.; Bushehri, A.A.S.; Hadian, J.; Maresca, V.; Sorbo, S.; Di Napoli, M.; Varcamonti, M.; Basile, A.; et al. Effect of Heat Stress on Yield, Monoterpene Content and Antibacterial Activity of Essential Oils of Mentha x piperita var. Mitcham and Mentha arvensis var. piperascens. Molecules 2018, 23, 1903. [Google Scholar] [CrossRef] [PubMed]
- Rasooli, I.; Rezaei, M.B.; Allameh, A. Ultrastructural studies on antimicrobial efficacy of thyme essential oils on Listeria monocytogenes. Int. J. Infect. Dis. 2006, 10, 236–241. [Google Scholar] [CrossRef]
- Turgis, M.; Han, J.; Caillet, S.; Lacroix, M. Antimicrobial activity of mustard essential oil against Escherichia coli O157:H7 and Salmonella typhi. Food Control 2009, 20, 1073–1079. [Google Scholar] [CrossRef]
- Paul, S.; Dubey, R.; Maheshwari, D.K.; Kang, S.C. Trachyspermum ammi (L.) fruit essential oil influencing on membrane permeability and surface characteristics in inhibiting food-borne pathogens. Food Control 2011, 22, 725–731. [Google Scholar] [CrossRef]
- Diao, W.-R.; Hu, Q.-P.; Zhang, H.; Xu, J.-G. Chemical composition, antibacterial activity and mechanism of action of essential oil from seeds of fennel (Foeniculum vulgare Mill.). Food Control 2014, 35, 109–116. [Google Scholar] [CrossRef]
- Llobet, E.; Campos, M.A.; Giménez, P.; Moranta, D.; Bengoechea, J.A. Analysis of the Networks Controlling the Antimicrobial-Peptide-Dependent Induction of Klebsiella pneumoniae Virulence Factors. Infect. Immun. 2011, 79, 3718–3732. [Google Scholar] [CrossRef]
- Sertel, S.; Eichhorn, T.; Plinkert, P.K.; Efferth, T. Cytotoxicity of Thymus vulgaris essential oil towards human oral cavity squamous cell carcinoma. Anticancer Res. 2011, 31, 81–87. [Google Scholar]
- Giongo, J.L.; Vaucher, R.A.; Da Silva, A.S.; Oliveira, C.B.; De Mattos, C.B.; Baldissera, M.D.; Sagrillo, M.R.; Monteiro, S.G.; Custódio, D.L.; De Matos, M.S.; et al. Trypanocidal activity of the compounds present in Aniba canelilla oil against Trypanosoma evansi and its effects on viability of lymphocytes. Microb. Pathog. 2017, 103, 13–18. [Google Scholar] [CrossRef]
- Abu-Darwish, M.S.; Cabral, C.; Ferreira, I.; Gonçalves, M.J.; Cavaleiro, C.; Cruz, M.T.; Al-Bdour, T.H.; Salgueiro, L. Essential Oil of Common Sage (Salvia officinalisL.) from Jordan: Assessment of Safety in Mammalian Cells and Its Antifungal and Anti-Inflammatory Potential. BioMed Res. Int. 2013, 2013, 1–9. [Google Scholar] [CrossRef]
- Sinha, S.; Jothiramajayam, M.; Ghosh, M.; Mukherjee, A. Evaluation of toxicity of essential oils palmarosa, citronella, lemongrass and vetiver in human lymphocytes. Food Chem. Toxicol. 2014, 68, 71–77. [Google Scholar] [CrossRef]
- Prashar, A.; Locke, I.C.; Evans, C.S. Cytotoxicity of lavender oil and its major components to human skin cells. Cell Prolif. 2004, 37, 221–229. [Google Scholar] [CrossRef]

| Constituents | LRI | O. glandulosum | L. dentata |
|---|---|---|---|
| α-thujene | 933 | 0.9 | 7.2 |
| α-pinene | 941 | 0.6 | |
| camphene | 955 | 1.0 | |
| thuja-2,4(10)-diene | 959 | 0.4 | |
| 1-octen-3-ol | 981 | 0.3 | |
| β-pinene | 982 | 0.2 | 17.3 |
| 3-octanone | 987 | 0.2 | |
| myrcene | 992 | 1.4 | |
| α-phellandrene | 1006 | 0.2 | |
| α-terpinene | 1020 | 2.9 | |
| p-cymene | 1028 | 16.1 | 1.1 |
| limonene | 1032 | 0.5 | 5.1 |
| 1,8-cineole | 1034 | 6.1 | |
| γ-terpinene | 1063 | 25.4 | |
| cis-linalool oxide (furanoid) | 1076 | 0.3 | |
| terpinolene | 1090 | 0.8 | |
| linalool | 1101 | 0.6 | 6.8 |
| hotrienol | 1103 | 0.2 | |
| endo-fenchol | 1112 | 0.2 | |
| cis-p-menth-2-en-1-ol | 1123 | 0.6 | |
| α-campholenal | 1125 | 1.2 | |
| trans-pinocarveol | 1141 | 8.7 | |
| cis-verbenol | 1142 | 0.4 | |
| trans-verbenol | 1143 | 2.2 | |
| pinocarvone | 1164 | 4.1 | |
| Borneol | 1167 | 0.1 | 1.7 |
| p-mentha-1,5-dien-8-ol | 1168 | 0.5 | |
| 4-terpineol | 1179 | 0.6 | 0.9 |
| cryptone | 1185 | 3.6 | |
| α-terpineol | 1191 | 0.4 | 1.0 |
| myrtenal | 1194 | 10.2 | |
| Verbenone | 1207 | 0.3 | |
| trans-carveol | 1220 | 1.1 | |
| methyl thymol | 1234 | 0.1 | |
| cuminaldehyde | 1241 | 3.9 | |
| carvone | 1244 | 1.6 | |
| methylcarvacrol | 1245 | 0.2 | |
| piperitone | 1254 | 0.6 | |
| phellandral | 1272 | 0.8 | |
| bornylacetate | 1287 | ||
| p-cymen-7-ol (syn. cumin alcohol) | 1290 | 0.7 | |
| thymol | 1291 | 33.1 | |
| p-mentha-1,8-dien-7-ol (syn. perilla alcohol) | 1297 | 0.5 | |
| carvacrol | 1299 | 13.0 | |
| (E)-3-hexenyl (E)-2-methylbut-2-enoate | 1325 | 0.4 | |
| β-caryophyllene | 1419 | 1.5 | 0.2 |
| β-selinene | 1487 | 1.1 | |
| β-bisabolene | 1508 | 0.2 | |
| trans-γ-cadinene | 1514 | 0.2 | |
| trans-calamenene | 1523 | 0.5 | |
| β-sesquiphellandrene | 1525 | 1.2 | |
| caryophyllene oxide | 1582 | 0.2 | 0.4 |
| β-eudesmol | 1650 | 1.6 | |
| α-bisabolol oxide B | 1654 | 0.5 | |
| cadalene | 1673 | 0.4 | |
| α-bisabolol | 1686 | 0.2 | |
| cis-14-nor-muurol-5-en-4-one | 1687 | 1.5 | |
| monoterpene hydrocarbons | 48.2 | 32.9 | |
| oxygenated monoterpenes | 48.1 | 54.6 | |
| sesquiterpene hydrocarbons | 2.9 | 2.4 | |
| oxygenated sesquiterpenes | 0.2 | 4.2 | |
| Diterpenes | 0.0 | 0.0 | |
| non-terpene derivatives | 0.5 | 4.0 | |
| Total identified | 99.9 | 98.1 |
| O. glandulosum | L. dentata | ||||
|---|---|---|---|---|---|
| Inhibition Zone | MIC | MBC | Inhibition Zone | MIC | MBC |
| 43.5 ± 6.7 | 5.2 ± 3.3 | 7.4 ± 5.1 | 9.3 ± 0.9 | 40.6 ± 25.5 | 48.1 ± 25.7 |
| Absorbance (260 nm) | |
|---|---|
| Control | 0.003 ± 0.001 a |
| O. glandulosum | 1.466 ± 0.048 b |
| L. dentata | 1.345 ± 0.048 c |
Publisher’s Note: MDPI stays neutral with regard to jurisdictional claims in published maps and institutional affiliations. |
© 2021 by the authors. Licensee MDPI, Basel, Switzerland. This article is an open access article distributed under the terms and conditions of the Creative Commons Attribution (CC BY) license (https://creativecommons.org/licenses/by/4.0/).
Share and Cite
Benbrahim, C.; Barka, M.S.; Basile, A.; Maresca, V.; Flamini, G.; Sorbo, S.; Carraturo, F.; Notariale, R.; Piscopo, M.; Khadir, A.; et al. Chemical Composition and Biological Activities of Oregano and Lavender Essential Oils. Appl. Sci. 2021, 11, 5688. https://doi.org/10.3390/app11125688
Benbrahim C, Barka MS, Basile A, Maresca V, Flamini G, Sorbo S, Carraturo F, Notariale R, Piscopo M, Khadir A, et al. Chemical Composition and Biological Activities of Oregano and Lavender Essential Oils. Applied Sciences. 2021; 11(12):5688. https://doi.org/10.3390/app11125688
Chicago/Turabian StyleBenbrahim, Chahla, Mohammed Salih Barka, Adriana Basile, Viviana Maresca, Guido Flamini, Sergio Sorbo, Federica Carraturo, Rosaria Notariale, Marina Piscopo, Abdelmounaim Khadir, and et al. 2021. "Chemical Composition and Biological Activities of Oregano and Lavender Essential Oils" Applied Sciences 11, no. 12: 5688. https://doi.org/10.3390/app11125688
APA StyleBenbrahim, C., Barka, M. S., Basile, A., Maresca, V., Flamini, G., Sorbo, S., Carraturo, F., Notariale, R., Piscopo, M., Khadir, A., Zatout, A., & Mechaala, S. (2021). Chemical Composition and Biological Activities of Oregano and Lavender Essential Oils. Applied Sciences, 11(12), 5688. https://doi.org/10.3390/app11125688

